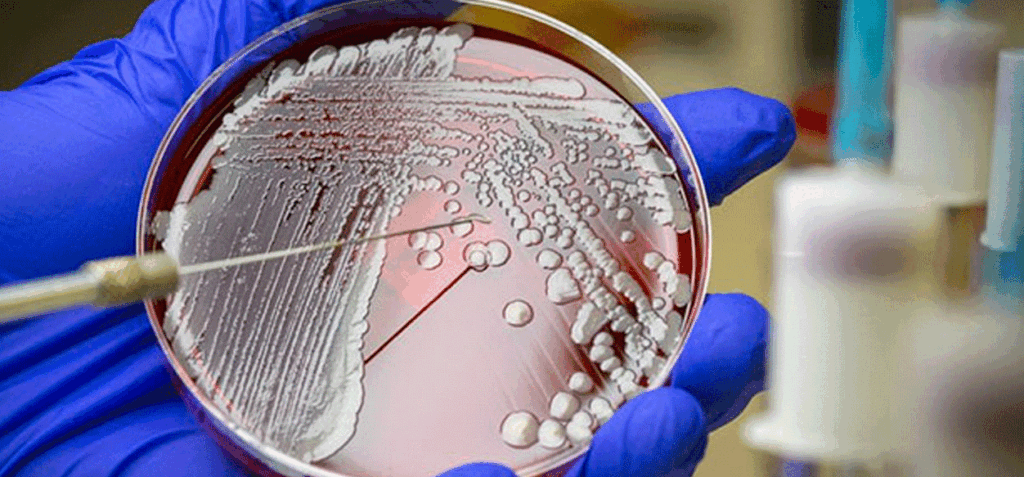

Los investigadores crearon aproximadamente 50.000 moléculas candidatas con este sistema y las seleccionaron mediante filtros basados en IA
La IA logra desarrollar antibióticos eficaces contra bacterias resistentes en ratones –. Investigadores de la Universidad de Pensilvania (Estados Unidos) han logrado desarrollar un sistema de inteligencia artificial capaz de diseñar antibióticos completamente nuevos y que han conseguido eliminar bacterias resistentes a los fármacos en ratones.
El trabajo de los investigadores, cuyos resultados se han publicado hoy en la revista Cell Biomaterials, ha conducido a la creación de una herramienta de inteligencia artificial generativa (que han bautizado como ‘AMP-Diffusion’) capaz de estudiar gigantescas colecciones de moléculas antimicrobianas sintéticas y de proponer candidatos a convertirse en nuevos antibióticos.
La investigación ha sido dirigida por el español César de la Fuente, catedrático de la Universidad de Pensilvania -donde dirige el Grupo de Biología de Máquinas- y Pranam Chatterjee, profesor de bioingeniería y ciencias de la computación, y los científicos han comprobado que en modelos de ratón con infección cutánea los compuestos más efectivos diseñados mediante inteligencia artificial mostraron un rendimiento comparable al de antibióticos ya aprobados por la Agencia del Medicamento y no presentaron efectos adversos.
Leer también: Los mamuts que habitaron en lo que hoy es México revelan secretos a través de su ADN
La herramienta que han desarrollado utiliza la “gramática” aprendida de las proteínas para proponer secuencias biológicamente plausibles, al mismo tiempo que optimiza la actividad antimicrobiana y otras propiedades relevantes para el desarrollo de fármacos, ha explicado la Universidad de Pensilvania en una nota de prensa.
“El conjunto de datos de la naturaleza es finito, pero con la inteligencia artificial podemos diseñar antibióticos que la evolución nunca intentó” ha asegurado De la Fuente. Y ha valorado que este proyecto ha demostrado que las máquinas pueden inventar nuevos antibióticos desde cero, abriendo una nueva frontera en el desarrollo de fármacos.
De los 46 candidatos principales que fueron sintetizados y sometidos a pruebas experimentales, dos demostraron ser capaces de reducir infecciones cutáneas resistentes a los medicamentos en ratones. Con una eficacia comparable a la de los antibióticos clínicos actuales, sin que se detectaran signos de toxicidad en los estudios.
“Esto es una prueba de principio de que la IA generativa puede crear nuevos antibióticos eficaces”, ha asegurado Chatterjee. Y ha celebrado que los resultados “apuntan a una vía para desarrollar con rapidez terapias que aborden la creciente amenaza de la resistencia a los antibióticos.”
EO// con información de: El Aragüeño
